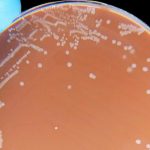

U.K. Suffers High Death Toll Despite Massive Spending to Combat Covid
October 4, 2021 7:00 am 68 CommentsDespite spectacular levels of spending and impressive vaccination rates, the U.K. has fared poorly in the pandemic compared both to one of Europe's poorer countries and to other island nations.